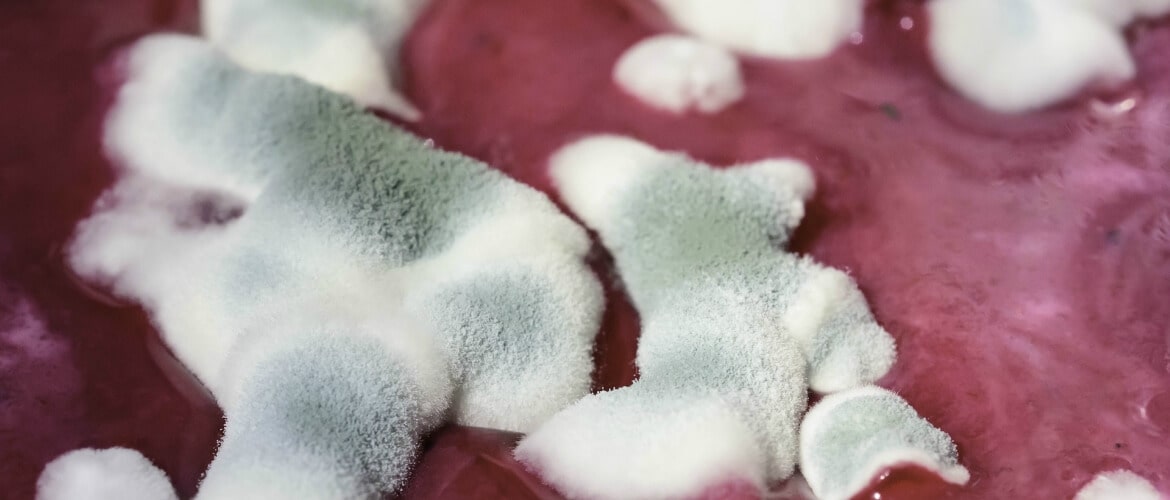

Disinfestazione
Disinfestazione da microrganismi patogeni, cimici da letto, acari, blatte, muffe e tarme.
Questa operazione richiede una importante emissione di ozono mirata ad eliminare totalmente l'infestazione.Solitamente è sufficiente una singola operazione, ma nel caso ne occorra una ulteriore seconda, essa è completamente gratuita. I risultati sono estremamente efficaci ed ecologici, dal momento che non vengono utilizzati pericolosi e dannosi insetticidi. Nel caso di muffe, assieme all'azione di ozonizzazione viene eseguita anche una potente operazione di deumidificazione per debellare il problema. Rispetto alle classiche disinfestazioni, le nostre offerte, oltre che essere altamente competitive, sono anche più ecologiche e naturali. Questi trattamenti vengono eseguiti sempre in assenza di persone.